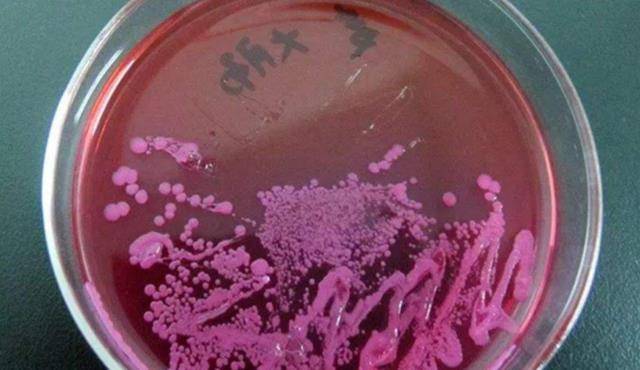

科学家为“永生”,与女模特一起注射350万年前细菌,后来怎样?
如果有个机会可以实现永生,但代价未知,有可能是付出生命,你会去尝试吗?
俄罗斯莫斯科有位名叫阿纳托利布·布鲁什科夫的科学家,便通过一种很冒险的方式去验证人类其实是可以实现永生的。

而这种方式,就是给自己注射猛犸象体内存有的350万年前的细菌,即芽孢杆菌F。
作为普通人的我们,深知细菌与病毒是人体避而不及的,一旦感染上未知的病菌,轻则影响健康,重则波及生命。
然而这位科学家却并不惧怕感染细菌所带来的一系列副作用,他不仅给自己注射了芽孢杆菌,还拉着一位女模特一起做了实验。

那么这科学家和女模特的实验结果是怎样的?究竟是验证了永生的可行性,还是付出了惨痛的代价呢?
阿纳托利布是莫斯科国立大学地球科学系的主任,同时也是俄罗斯颇具权威性的科学家,所以在业内他的学术研究一般都有着极高的关注度。
对于永生的实验,其实是源自一次意外的发现,这次发现让他了解了细菌顽强的生命力,进而突发奇想试图用人体来做实验。
时间来到2009年的某一天,阿纳托利布于往日一样进行科学研究,他发现栖息在西伯利亚某地的猛犸象体内存有一种细菌,即芽孢杆菌,竟然活了三百五十万年。
猛犸象早就没有了生命体征,且时间又过了上百年,,是什么细菌能有如此顽强的生命力?这让阿纳托利布十分疑惑。
与此同时,这个新发现也使得阿纳托利布兴奋非常,于是他便投入到了对芽孢杆菌的研究之中。

为了测试芽孢杆菌的性能,他先后给一些农作物注射了细菌,而在经过一段时间的生长之后,阿纳托利将注射过细菌的农作物和未注射过细菌的农作进行了对比。
他发现感染过细菌的农作物明显要生长得更快,且其本身的抗旱与耐霜冻的能力,也要强于正常的农作物。
当然,仅这一项实验还不足以证明什么,于是阿纳托利又找来了果蝇和老鼠,他将细菌注射到了这些活物体内。

在经过一段时间的观察后,阿纳托利发现果蝇和老鼠并没有因为感染细菌而出现器官衰竭等各种异常的反应,且生命体反而拥有了更强的繁殖能力。
而让人最为意外的是,一只已经进入“老年”的老鼠,竟然在注射了细菌之后,重新有了生育的能力。
种种发现让阿纳托利激动不已,随后他便想深入了解,如果将这种细菌注入人体会有何种反应?

阿纳托利先是去西伯利亚芽孢杆菌的发现地做了一个简单的调查,发现在这里生活的居民普遍长寿,于是乎他便猜测这很有可能是因为芽孢杆菌的影响。
虽然这只是一种猜测,但阿纳托利却觉得芽孢杆菌的生长机制很特别,细菌本身可以存活上百年,且又能加强其他生命体的各项性能,那人类也许也能从中受益。
最终在下定了决心后,阿纳托利便将芽孢杆菌注射到了自己的体内,他相信只要利用细菌的生存方式,就可以延长人类的寿命,甚至可以实现永生。

阿纳托利自我‘’牺牲“的”疯狂举动,震惊了科研界,因为这项实验一旦失败,很有可能赔上性命。
所以在实验期,阿纳托利的一举一动都是焦点,大家都尤为担心他的身体状态,所幸的是,阿纳托利并没有异常的反应,且在之后的2年时间里,身体机能一切正常。
不仅没有副作用,阿纳托利甚至发现自己要比往年更加强壮,连精神状态也要好上很多,很少有感到疲惫的时候。

阿纳托利的健康并没有受到任何影响,这让科研界的人松了一口气,于此同时,越来越多的人开始关注这项永生实验。
在2017年,有一位来自慕尼黑的女模特马努什,自告奋勇地想要加入这场实验之中,最终她也被注射了芽孢杆菌。
至今这位女模特也并没有任何的身体异常,而阿纳托利也在持续地关注自己和马努什的身体以及精神状态。

早在进行芽孢杆菌的永生实验之前,人类就有过往自己体内注射细菌的案例,甚至发展到今天已经成为了普遍现象,也就是女明星们所推崇的肉毒杆菌。
对于那些上了年纪的女性而言,肉毒杆菌是维持美貌的良药,可以在一定时间内保证肌肤的状态,减缓衰老速度。
不过,细菌毕竟是危险的生命体,具有不可控性,所以肉毒杆菌的使用也是比较危险的,只是相比芽孢杆菌,大众对肉毒杆菌的接受度更高一些。

截止到目前为止,芽孢杆菌的研究也没有一个新的进展,只知道人体在注射这种细菌后并没有出现明显的副作用。
但至于它是否具有百分百的安全性,以及是否真的能够延长人类的寿命,科研界还没法给出一个明确的答案。
“永生”只是理想,永远不会实现?
想要实现长寿呢,最直观的办法就是减少身体病症,只要人类具有细菌病毒都攻不破的免疫力,就能延长生命。

所以经常在公园中健身的大爷大妈,基本上都很少生病,而那些整日不下楼,缺乏锻炼的人,则是小毛病不断。
但免疫力即便再强,也只是能起到防护作用,经常锻炼,作息正常,饮食健康最多能延长几年甚至十几年寿命,却并没有办法实现永生。
除此外,只要人体的端粒酶多分裂也可以延长生命,不过端粒酶分裂得越多,细胞就会越多,一旦形成恶性细胞,就会引发癌症。

所以,到目前为止,“永生”始终是不可实现的理想,人可以通过各种方式来延长寿命,但延长的时间却有限。
”盛年不重来,一日难再晨”
人类想实现永生并没有错,但也不要过于痴迷于不切实际的理想,将有限且珍贵的时间都虚度掉。

相比痴迷永生,在有限的时间里去追求更多有意义的事要更为重要,毕竟光阴流逝便再也回不来。
有的人80岁还一事无成,然而有的人到80岁却是“活到老学到老”,珍惜眼下的每一天,不要等到了人生的最后阶段,再回首往昔时而追悔莫及。
大家都在看
-
中国四大未解之谜,至今无人能破解 我前两天在图书馆翻旧书,偶然看到一本1982年影印的《清宫医案研究》,里头同治那页缺了两行,纸角发脆,被人用铅笔轻轻圈了个“?”旁边还有一行小字:“此页原缺,据光绪朝抄本补,存疑。”我盯着看了好几分钟,不 ... 未解之谜06-16
-
从全民热议到无人问津,风靡全球的三大未解之谜,全是百年骗局? 文/编辑:老张鉴语在十几年前的互联网和书刊杂志中,百慕大三角、尼斯湖水怪、复活节岛石像等未解之谜,是无数人津津乐道的神秘话题。这些自带奇幻色彩的传说言之凿凿,搭配离奇的目击事件与无解的现场细节,一度被大 ... 未解之谜06-13
-
中国四大未解之谜!千百年争论不休,至今无标准答案 漫漫历史长河中,留存着诸多扑朔迷离的谜团。有不少历史事件很知名,但记载模糊、说法各异,后世学者反复考证、民间众说纷纭,却始终无法拨开层层迷雾。今天列举其中四大经典未解之谜,每一件都疑点丛生,千百年来无 ... 未解之谜06-11
-
世界五大未解之谜,每个都令人赞叹不已 1、纳特龙湖之谜在坦桑尼亚的北部有片湖,湖水颜色通红,碱性特别强,温度动不动就飙升到极高。有不少鸟儿掉进湖里死后慢慢变成像石头一样的干尸,当地一直在传只要沾到湖里的水,动物立马会变成石像。相关的地理和 ... 未解之谜06-09
-
我国十大考古未解之谜,件件匪夷所思,谜团背后藏着惊天真相 华夏上下五千年,史册记下的故事不过冰山一角,太多古人秘事、奇绝手艺、失落国宝,被岁月深埋泥土,变成一桩桩百思不解的考古谜团。一代代考古学者踏遍大江南北,靠着现代仪器、史料典籍反复推敲,不少谜题依旧众说 ... 未解之谜06-08
-
这五大中国“未解之谜”,已被专家解开了 原创:认真生活的女孩原发:生活精选学(微信公众号)1、内蒙古巨石“自转”之谜在内蒙古的大草原上,矗立着一块重达数吨的巨石。这块石块的特别之处就是它的位置不仅会悄悄偏移,看起来还像是在原地转动的。时间长 ... 未解之谜06-08
-
历史长河中的未解之谜:那些至今让人困惑的秘密 一、亚特兰蒂斯:失落的文明之亚特兰蒂斯是古希腊哲学家柏拉图在其著作中提到的一个高度发达的古代文明。据说,亚特兰蒂斯拥有先进的科技和繁荣的社会,但因灾难性的地震和海啸而沉没于海底。尽管现代科学家和探险家 ... 未解之谜05-29
-
中国历史五大未解之谜,至今无合理解释,你知道几个? 中华上下五千年,留下了无数璀璨的文明瑰宝,也留下了诸多令人费解的谜团。它们跨越千年,历经岁月冲刷,依旧没有权威、合理的解释,吸引着无数史学家、考古学家前赴后继地探索。以下这五大未解之谜,堪称中国历史上 ... 未解之谜05-25
-
韩系冷门限制级神作《未解之谜:失踪》 哈喽各位吃瓜追剧的小伙伴!道哥在线挖冷门好片,拒绝烂片踩雷!✨提起韩国限制级电影,很多人的第一刻板印象就是:尺度大、无营养、靠噱头博眼球。说实话,作为常年阅片无数的女博主,我以前也是这么想的,一直对这 ... 未解之谜05-25
-
颠覆认知的中国历史未解之谜,专家研究千年,至今无人破解 你敢相信吗?中华上下五千年,无数史书典籍记录王朝更迭、人间百态,却偏偏留下四大诡异谜团。它们超脱常理、违背时代逻辑,无数历史学家、考古专家穷尽毕生精力研究,至今没有标准答案,每一个都足以颠覆我们对古代 ... 未解之谜05-21
相关文章
- 历史四大未解之谜,至今无人破解
- 爱泼斯坦“遗书”曝光:一句“什么也没发现”背后,藏着多少未解之谜
- 明朝六个未解之谜,至今仍未能知道真相,最后一个贯穿整个明朝。
- 历史上3大未解之谜,每一个都超乎想象
- 《蜜语纪》大结局过后,留下了4处未解之谜
- 中国历史上的四大未解之谜
- 中国十大未解之谜!百年古尸贴有黄符,六祖慧能千年肉身不腐
- 中国历史上3大未解之谜:一个比一个诡异,最后一个至今无人能解
- 华夏千古未解之谜一个凭空消失一个下落成迷 真相至今无人敢下定论
- 这5个未解之谜,已经被解开了
- 历史长河中的十大未解之谜:穿越千年的迷雾与回响
- 四足动物肢体姿势转变与体型演化如何关联?最新研究揭开未解之谜
- 夜读丨体育老师的“未解之谜”
- 中国历史上3大未解之谜,第2个中国一大遗憾,第3个没人说得清楚
- 相声界三大未解之谜,困扰江湖几十年,至今没人能说清
- 宇宙6大未解之谜,科学家认为:可能人类永远找不到答案
- 中国七大未解之谜:件件颠覆认知,千年无人破解,真相细思极恐
- 人类的十大未解之谜:你的寒假作业,写了吗?
- 宇宙7大未解之谜,科学家承认:可能人类永远都找不到答案
- 中国至今未解之谜,迷一样的历史,迷一样的历史
热门阅读
-
119碎尸案,场面让人震惊,胆小者勿入 07-11
-
96年南大碎尸案,刁爱青被杀后整齐切了两千多刀 07-11
-
南大碎尸案史上最惨案件,揭开陈年悬案的真相! 07-11
-
历史上10件真实神秘失踪事件,揭秘人类失踪之谜 01-30
-
韩国三大悬案,韩国三大悬案之首告破 05-06
-
长生不老药已研制成功,人类可以长生不老 08-13
